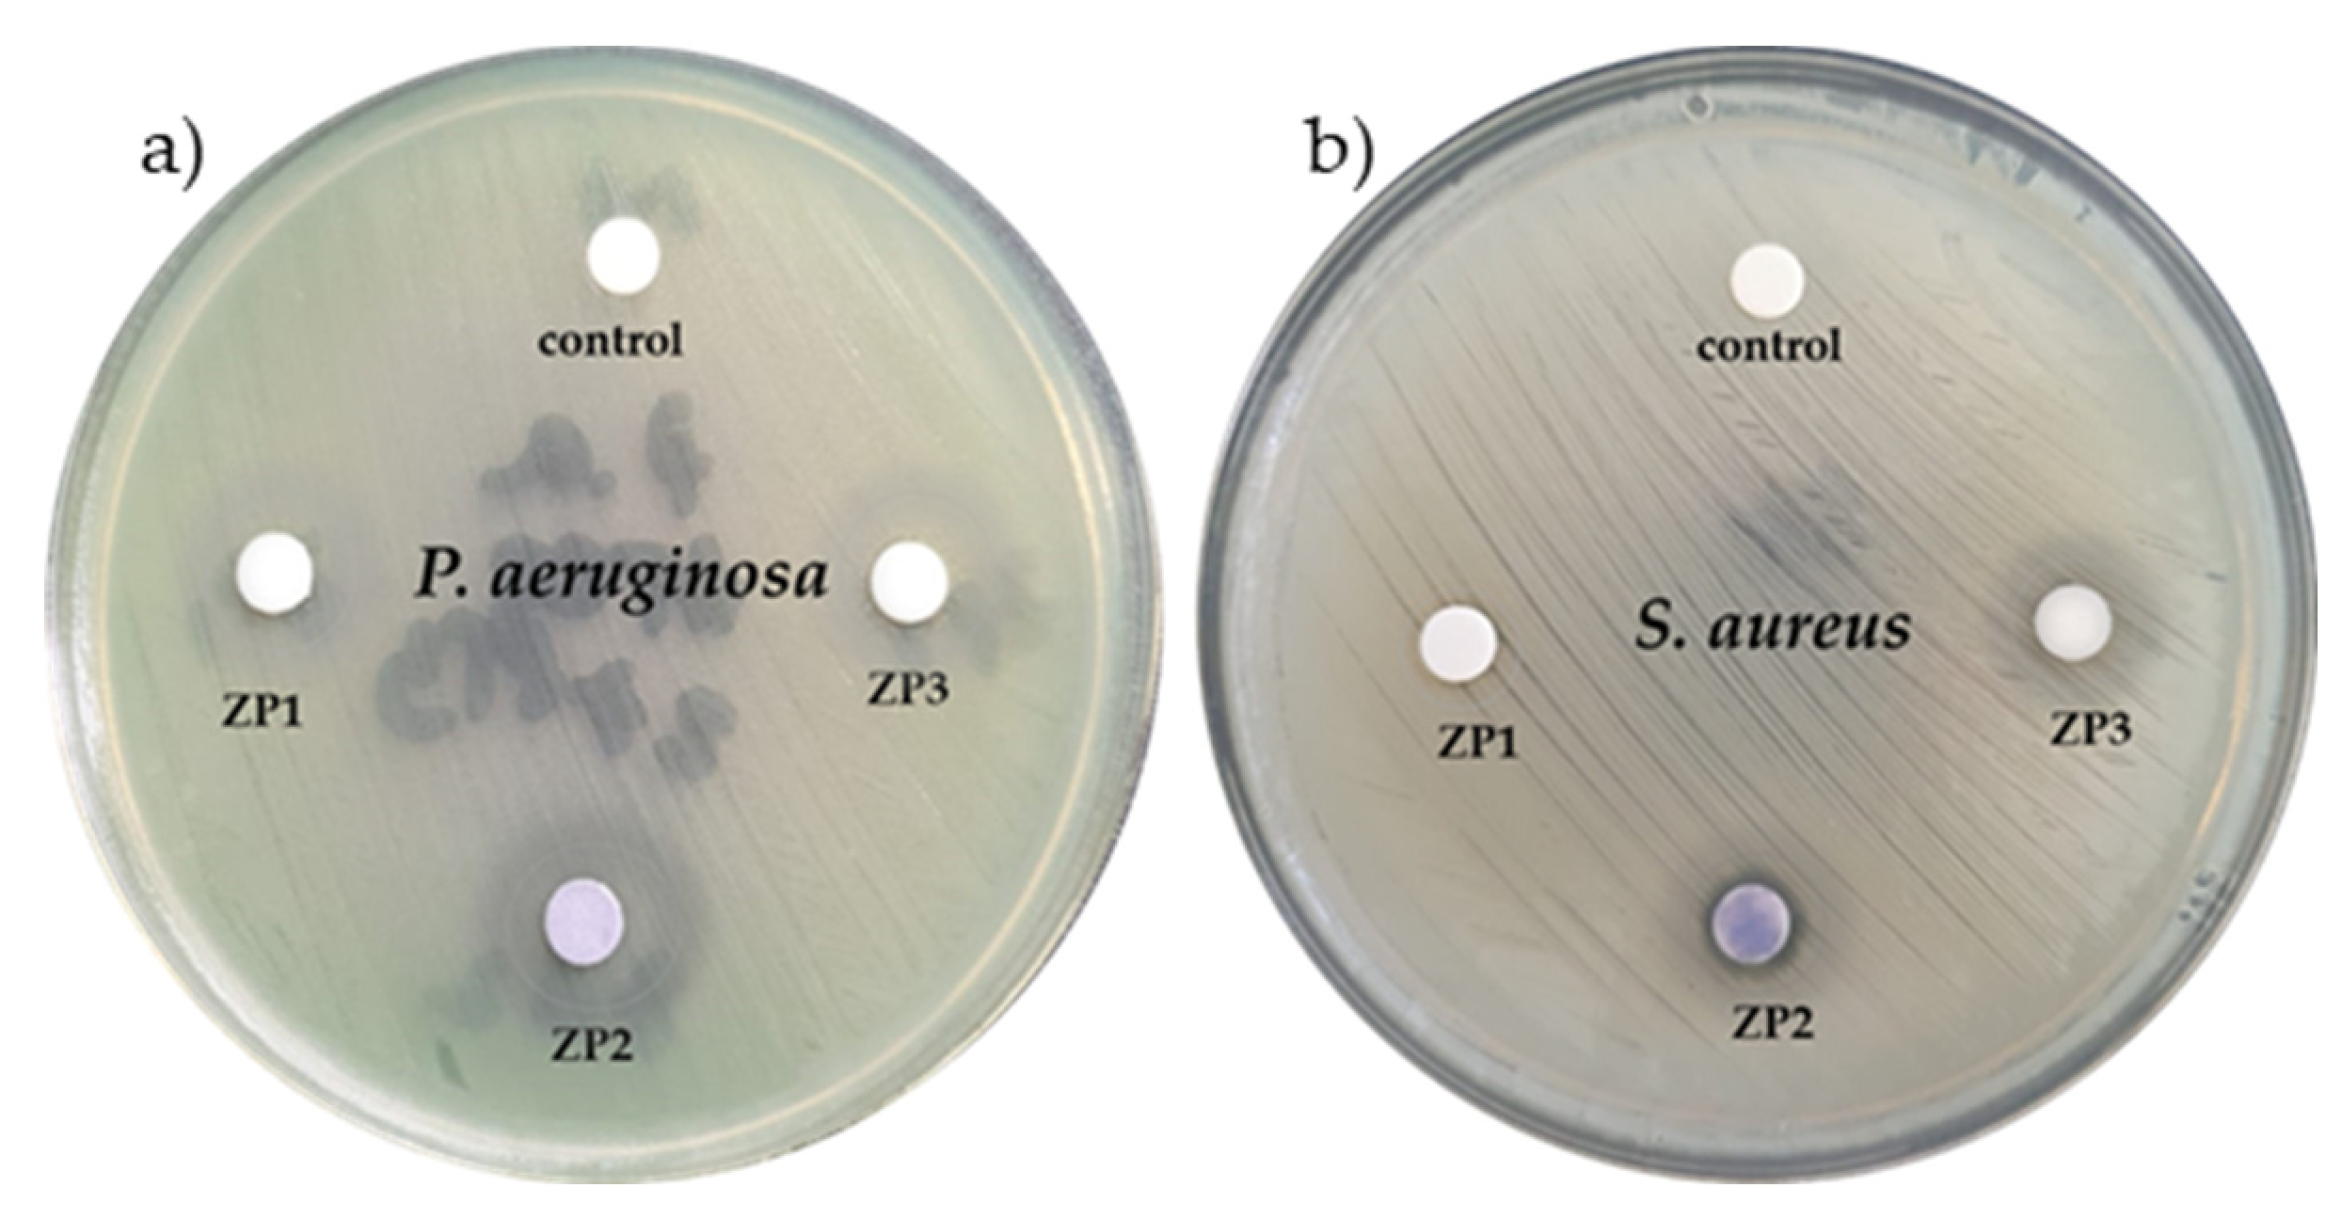
Ijms 24 16939 g005

Antibacterial and Photocatalytic Activity of ZnO/Au and ZnO/Ag Nanocomposites
Abstract
:1. Introduction
2. Results and Discussion
2.1. Characterization of the ZnO/Au and ZnO/Ag Nanocomposites
2.2. Optical Properties
2.3. Antimicrobial Activity
2.4. Photocatalytic Activity
3. Materials and Methods
3.1. Reagents
3.2. Preparation of ZnO/Au and ZnO/Ag Nanocomposites
3.3. Characterization Techniques
3.4. Antibacterial Testing
3.4.1. Antibacterial Susceptibility
3.4.2. Minimum Inhibitory Concentration (MIC) and Minimum Bactericidal Concentration (MBC) Assays
3.5. Photocatalytic Testing
3.6. Statistical Analysis
4. Conclusions
Supplementary Materials
Author Contributions
Funding
Institutional Review Board Statement
Informed Consent Statement
Data Availability Statement
Conflicts of Interest
References
- Pelaz, B.; Alexiou, C.; Alvarez-Puebla, R.A.; Alves, F.; Andrews, A.M.; Ashraf, S.; Balogh, L.P.; Ballerini, L.; Bestetti, A.; Brendel, C. Diverse applications of nanomedicine. ACS Nano 2017, 11, 2313–2381. [Google Scholar] [CrossRef] [PubMed]
- Hasnat, M.A.; Hossain, M.I.; Ahsan, M.; Islam, M.F. Recent Developments in the Utilization of Nanomaterials for Sensing Platforms. Recent Dev. Green Electrochem. Sens. Des. Perform. Appl. 2023, 1437, 61–99. [Google Scholar]
- Kumar, R.; Kumar, M.; Luthra, G. Fundamental approaches and applications of nanotechnology: A mini-review. Mater. Today Proc. 2023, in press. [Google Scholar] [CrossRef]
- Xia, Y.; Xiong, Y.; Lim, B.; Skrabalak, S.E. Shape-controlled synthesis of metal nanocrystals: Simple chemistry meets complex physics? Angew. Chem. Int. Ed. 2009, 48, 60–103. [Google Scholar] [CrossRef] [PubMed]
- Behzadi, S.; Serpooshan, V.; Tao, W.; Hamaly, M.A.; Alkawareek, M.Y.; Dreaden, E.C.; Brown, D.; Alkilany, A.M.; Farokhzad, O.C.; Mahmoudi, M. Cellular uptake of nanoparticles: Journey inside the cell. Chem. Soc. Rev. 2017, 46, 4218–4244. [Google Scholar] [CrossRef] [PubMed]
- Hetta, H.F.; Ramadan, Y.N.; Al-Harbi, A.I.; Ahmed, E.A.; Battah, B.; Abd Ellah, N.H.; Zanetti, S.; Donadu, M.G. Nanotechnology as a Promising Approach to Combat Multidrug Resistant Bacteria: A Comprehensive Review and Future Perspectives. Biomedicines 2023, 11, 413. [Google Scholar] [CrossRef]
- Zhao, Y.; Chen, L.; Wang, Y.; Song, X.; Li, K.; Yan, X.; Yu, L.; He, Z. Nanomaterial-based strategies in antimicrobial applications: Progress and perspectives. Nano Res. 2021, 14, 4417–4441. [Google Scholar] [CrossRef]
- Dediu, V.; Ghitman, J.; Gradisteanu Pircalabioru, G.; Chan, K.H.; Iliescu, F.S.; Iliescu, C. Trends in Photothermal Nanostructures for Antimicrobial Applications. Int. J. Mol. Sci. 2023, 24, 9375. [Google Scholar] [CrossRef]
- Hosny, A.E.-D.M.; Rasmy, S.A.; Aboul-Magd, D.S.; Kashef, M.T.; El-Bazza, Z.E. The increasing threat of silver-resistance in clinical isolates from wounds and burns. Infect. Drug Resist. 2019, 12, 1985–2001. [Google Scholar] [CrossRef]
- Wu, Z.; Chan, B.; Low, J.; Chu, J.J.H.; Hey, H.W.D.; Tay, A. Microbial resistance to nanotechnologies: An important but understudied consideration using antimicrobial nanotechnologies in orthopaedic implants. Bioact. Mater. 2022, 16, 249–270. [Google Scholar] [CrossRef]
- Shaikh, S.; Nazam, N.; Rizvi, S.M.D.; Ahmad, K.; Baig, M.H.; Lee, E.J.; Choi, I. Mechanistic insights into the antimicrobial actions of metallic nanoparticles and their implications for multidrug resistance. Int. J. Mol. Sci. 2019, 20, 2468. [Google Scholar] [CrossRef] [PubMed]
- Kumar, R.; Umar, A.; Kumar, G.; Nalwa, H.S. Antimicrobial properties of ZnO nanomaterials: A review. Ceram. Int. 2017, 43, 3940–3961. [Google Scholar] [CrossRef]
- Karagoz, S.; Kiremitler, N.B.; Sarp, G.; Pekdemir, S.; Salem, S.; Goksu, A.G.; Onses, M.S.; Sozdutmaz, I.; Sahmetlioglu, E.; Ozkara, E.S. Antibacterial, antiviral, and self-cleaning mats with sensing capabilities based on electrospun nanofibers decorated with ZnO nanorods and Ag nanoparticles for protective clothing applications. ACS Appl. Mater. Interfaces 2021, 13, 5678–5690. [Google Scholar] [CrossRef] [PubMed]
- Gupta, J.; Irfan, M.; Ramgir, N.; Muthe, K.; Debnath, A.; Ansari, S.; Gandhi, J.; Ranjith-Kumar, C.; Surjit, M. Antiviral Activity of Zinc Oxide Nanoparticles and Tetrapods Against the Hepatitis E and Hepatitis C Viruses. Front. Microbiol. 2022, 13, 881595. [Google Scholar] [CrossRef]
- Melk, M.M.; El-Hawary, S.S.; Melek, F.R.; Saleh, D.O.; Ali, O.M.; El Raey, M.A.; Selim, N.M. Antiviral activity of zinc oxide nanoparticles mediated by plumbago indica L. Extract against herpes simplex virus type 1 (HSV-1). Int. J. Nanomed. 2021, 16, 8221. [Google Scholar] [CrossRef] [PubMed]
- Lipovsky, A.; Nitzan, Y.; Gedanken, A.; Lubart, R. Antifungal activity of ZnO nanoparticles—The role of ROS mediated cell injury. Nanotechnology 2011, 22, 105101. [Google Scholar] [CrossRef] [PubMed]
- Kumar, R.S.; Dananjaya, S.; De Zoysa, M.; Yang, M. Enhanced antifungal activity of Ni-doped ZnO nanostructures under dark conditions. RSC Adv. 2016, 6, 108468–108476. [Google Scholar] [CrossRef]
- Marín-Caba, L.; Bodelón, G.; Negrín-Montecelo, Y.; Correa-Duarte, M.A. Sunlight-sensitive plasmonic nanostructured composites as photocatalytic coating with antibacterial properties. Adv. Funct. Mater. 2021, 31, 2105807. [Google Scholar] [CrossRef]
- Lu, J.; Wang, H.; Peng, D.; Chen, T.; Dong, S.; Chang, Y. Synthesis and properties of Au/ZnO nanorods as a plasmonic photocatalyst. Phys. E Low-Dimens. Syst. Nanostructures 2016, 78, 41–48. [Google Scholar] [CrossRef]
- Kavitha, R.; Kumar, S.G. A review on plasmonic Au-ZnO heterojunction photocatalysts: Preparation, modifications and related charge carrier dynamics. Mater. Sci. Semicond. Process. 2019, 93, 59–91. [Google Scholar] [CrossRef]
- Balestri, A.; Cardellini, J.; Berti, D. Gold and Silver Nanoparticles as Tools to Combat Multidrug-Resistant Pathogens. Curr. Opin. Colloid Interface Sci. 2023, 66, 101710. [Google Scholar] [CrossRef]
- Dediu, V.; Busila, M.; Tucureanu, V.; Bucur, F.I.; Iliescu, F.S.; Brincoveanu, O.; Iliescu, C. Synthesis of ZnO/Au nanocomposite for antibacterial applications. Nanomaterials 2022, 12, 3832. [Google Scholar] [CrossRef] [PubMed]
- Hernández-Sierra, J.F.; Ruiz, F.; Pena, D.C.C.; Martínez-Gutiérrez, F.; Martínez, A.E.; Guillén, A.d.J.P.; Tapia-Pérez, H.; Castañón, G.M. The antimicrobial sensitivity of Streptococcus mutans to nanoparticles of silver, zinc oxide, and gold. Nanomed. Nanotechnol. Biol. Med. 2008, 4, 237–240. [Google Scholar] [CrossRef] [PubMed]
- Burlibaşa, L.; Chifiriuc, M.C.; Lungu, M.V.; Lungulescu, E.M.; Mitrea, S.; Sbarcea, G.; Popa, M.; Măruţescu, L.; Constantin, N.; Bleotu, C. Synthesis, physico-chemical characterization, antimicrobial activity and toxicological features of AgZnO nanoparticles. Arab. J. Chem. 2020, 13, 4180–4197. [Google Scholar] [CrossRef]
- Mousavi-Kouhi, S.M.; Beyk-Khormizi, A.; Amiri, M.S.; Mashreghi, M.; Yazdi, M.E.T. Silver-zinc oxide nanocomposite: From synthesis to antimicrobial and anticancer properties. Ceram. Int. 2021, 47, 21490–21497. [Google Scholar] [CrossRef]
- Ong, C.B.; Ng, L.Y.; Mohammad, A.W. A review of ZnO nanoparticles as solar photocatalysts: Synthesis, mechanisms and applications. Renew. Sustain. Energy Rev. 2018, 81, 536–551. [Google Scholar] [CrossRef]
- Zhang, X.; Chen, Y.L.; Liu, R.-S.; Tsai, D.P. Plasmonic photocatalysis. Rep. Prog. Phys. 2013, 76, 046401. [Google Scholar] [CrossRef]
- Deng, Q.; Duan, X.; Ng, D.H.; Tang, H.; Yang, Y.; Kong, M.; Wu, Z.; Cai, W.; Wang, G. Ag nanoparticle decorated nanoporous ZnO microrods and their enhanced photocatalytic activities. ACS Appl. Mater. Interfaces 2012, 4, 6030–6037. [Google Scholar] [CrossRef]
- Güy, N.; Özacar, M. The influence of noble metals on photocatalytic activity of ZnO for Congo red degradation. Int. J. Hydrogen Energy 2016, 41, 20100–20112. [Google Scholar] [CrossRef]
- Putri, A.E.; Roza, L.; Budi, S.; Umar, A.A.; Fauzia, V. Tuning the photocatalytic activity of nanocomposite ZnO nanorods by shape-controlling the bimetallic AuAg nanoparticles. Appl. Surf. Sci. 2021, 536, 147847. [Google Scholar] [CrossRef]
- Sun, F.; Tan, F.; Wang, W.; Qiao, X.; Qiu, X. Facile synthesis of Ag/ZnO heterostructure nanocrystals with enhanced photocatalytic performance. Mater. Res. Bull. 2012, 47, 3357–3361. [Google Scholar] [CrossRef]
- Ibănescu, M.; Muşat, V.; Textor, T.; Badilita, V.; Mahltig, B. Photocatalytic and antimicrobial Ag/ZnO nanocomposites for functionalization of textile fabrics. J. Alloys Compd. 2014, 610, 244–249. [Google Scholar] [CrossRef]
- Akman, B.; Aras, O. Usability, durability and regeneration of Ag/ZnO coated microreactor for photocatalytic degradation of methylene blue. J. Mol. Struct. 2022, 1251, 132003. [Google Scholar] [CrossRef]
- Lin, W.-H.; Chiu, Y.-H.; Shao, P.-W.; Hsu, Y.-J. Metal-particle-decorated ZnO nanocrystals: Photocatalysis and charge dynamics. ACS Appl. Mater. Interfaces 2016, 8, 32754–32763. [Google Scholar] [CrossRef]
- Pawinrat, P.; Mekasuwandumrong, O.; Panpranot, J. Synthesis of Au–ZnO and Pt–ZnO nanocomposites by one-step flame spray pyrolysis and its application for photocatalytic degradation of dyes. Catal. Commun. 2009, 10, 1380–1385. [Google Scholar] [CrossRef]
- Rietveld, H.M. A profile refinement method for nuclear and magnetic structures. J. Appl. Crystallogr. 1969, 2, 65–71. [Google Scholar] [CrossRef]
- Pecharsky, V.K.; Zavalij, P.Y. Fundamentals of Crystalline State and Crystal Lattice. In Fundamentals of Powder Diffraction and Structural Characterization of Materials; Springer: Berlin/Heidelberg, Germany, 2009; pp. 1–15. [Google Scholar]
- Williamson, G.; Smallman, R. III. Dislocation densities in some annealed and cold-worked metals from measurements on the X-ray debye-scherrer spectrum. Philos. Mag. 1956, 1, 34–46. [Google Scholar] [CrossRef]
- Kim, K.-M.; Choi, M.-H.; Lee, J.-K.; Jeong, J.; Kim, Y.-R.; Kim, M.-K.; Paek, S.-M.; Oh, J.-M. Physicochemical properties of surface charge-modified ZnO nanoparticles with different particle sizes. Int. J. Nanomed. 2014, 9, 41–56. [Google Scholar]
- Nicholas, N.J.; Franks, G.V.; Ducker, W.A. Selective adsorption to particular crystal faces of ZnO. Langmuir 2012, 28, 7189–7196. [Google Scholar] [CrossRef]
- Restrepo, C.V.; Villa, C.C. Synthesis of silver nanoparticles, influence of capping agents, and dependence on size and shape: A review. Environ. Nanotechnol. Monit. Manag. 2021, 15, 100428. [Google Scholar] [CrossRef]
- Hessien, M.; Da’na, E.; Kawther, A.; Khalaf, M.M. Nano ZnO (hexagonal wurtzite) of different shapes under various conditions: Fabrication and characterization. Mater. Res. Express 2019, 6, 085057. [Google Scholar] [CrossRef]
- Ţucureanu, V.; Munteanu, D. Enhanced optical properties of YAG: Ce yellow phosphor by modification with gold nanoparticles. Ceram. Int. 2019, 45, 7641–7648. [Google Scholar] [CrossRef]
- Fageria, P.; Gangopadhyay, S.; Pande, S. Synthesis of ZnO/Au and ZnO/Ag nanoparticles and their photocatalytic application using UV and visible light. Rsc Adv. 2014, 4, 24962–24972. [Google Scholar] [CrossRef]
- Abdullahi, S.S.; Güner, S.; Musa, Y.; Adamu, B.I.; Abdulhamid, M.I. Sımple method for the determınatıon of band gap of a nanopowdered sample usıng Kubelka Munk theory. NAMP J. 2016, 35, 241–246. [Google Scholar]
- Patel, J.B. Performance Standards for Antimicrobial Susceptibility Testing; twenty-fifth informational supplement; Clinical & Laboratory Standards Institute: Malvern, PA, USA, 2015. [Google Scholar]
- Kassim, A.; Omuse, G.; Premji, Z.; Revathi, G. Comparison of Clinical Laboratory Standards Institute and European Committee on Antimicrobial Susceptibility Testing guidelines for the interpretation of antibiotic susceptibility at a University teaching hospital in Nairobi, Kenya: A cross-sectional study. Ann. Clin. Microbiol. Antimicrob. 2016, 15, 21. [Google Scholar] [CrossRef]
- Parvekar, P.; Palaskar, J.; Metgud, S.; Maria, R.; Dutta, S. The minimum inhibitory concentration (MIC) and minimum bactericidal concentration (MBC) of silver nanoparticles against Staphylococcus aureus. Biomater. Investig. Dent. 2020, 7, 105–109. [Google Scholar] [CrossRef] [PubMed]
- Niño-Martínez, N.; Salas Orozco, M.F.; Martínez-Castañón, G.-A.; Torres Méndez, F.; Ruiz, F. Molecular mechanisms of bacterial resistance to metal and metal oxide nanoparticles. Int. J. Mol. Sci. 2019, 20, 2808. [Google Scholar] [CrossRef]
- Hachicho, N.; Hoffmann, P.; Ahlert, K.; Heipieper, H.J. Effect of silver nanoparticles and silver ions on growth and adaptive response mechanisms of Pseudomonas putida mt-2. FEMS Microbiol. Lett. 2014, 355, 71–77. [Google Scholar] [CrossRef]
- Regmi, C.; Joshi, B.; Ray, S.K.; Gyawali, G.; Pandey, R.P. Understanding mechanism of photocatalytic microbial decontamination of environmental wastewater. Front. Chem. 2018, 6, 33. [Google Scholar] [CrossRef]
- Reidy, B.; Haase, A.; Luch, A.; Dawson, K.A.; Lynch, I. Mechanisms of silver nanoparticle release, transformation and toxicity: A critical review of current knowledge and recommendations for future studies and applications. Materials 2013, 6, 2295–2350. [Google Scholar] [CrossRef]
- Tian, E.-K.; Wang, Y.; Ren, R.; Zheng, W.; Liao, W. Gold nanoparticle: Recent progress on its antibacterial applications and mechanisms. J. Nanomater. 2021, 2021, 1–18. [Google Scholar] [CrossRef]
- Dasari, T.S.; Zhang, Y.; Yu, H. Antibacterial activity and cytotoxicity of gold (I) and (III) ions and gold nanoparticles. Biochem. Pharmacol. Open Access 2015, 4, 199. [Google Scholar] [CrossRef] [PubMed]
- Lee, H.; Lee, D.G. Gold nanoparticles induce a reactive oxygen species-independent apoptotic pathway in Escherichia coli. Colloids Surf. B Biointerfaces 2018, 167, 1–7. [Google Scholar] [CrossRef] [PubMed]
- Lipovsky, A.; Tzitrinovich, Z.; Friedmann, H.; Applerot, G.; Gedanken, A.; Lubart, R. EPR study of visible light-induced ROS generation by nanoparticles of ZnO. J. Phys. Chem. C 2009, 113, 15997–16001. [Google Scholar] [CrossRef]
- Pham, T.N.; Hue, N.T.; Lee, Y.-C.; Huy, T.Q.; Thuy, N.T.T.; Van Tuan, H.; Khi, N.T.; Phan, V.N.; Thanh, T.D.; Lam, V.D. A hybrid design of Ag-decorated ZnO on layered nanomaterials (MgAC) with photocatalytic and antibacterial dual-functional abilities. RSC Adv. 2021, 11, 38578–38588. [Google Scholar] [CrossRef]
- Banerjee, S.; Pillai, S.C.; Falaras, P.; O’shea, K.E.; Byrne, J.A.; Dionysiou, D.D. New insights into the mechanism of visible light photocatalysis. J. Phys. Chem. Lett. 2014, 5, 2543–2554. [Google Scholar] [CrossRef]

| Sample Code | Nanomaterials | |
|---|---|---|
| ZP1 | citrate-functionalized ZnO | ![]() |
| ZP2 | ZnO/Au nanocomposite | |
| ZP3 | ZnO/Ag nanocomposite |
| Sample | Unit Cell Parameters (nm) | Crystallite Size (nm) | Rwp % | S | Lattice Strain (%) | |
|---|---|---|---|---|---|---|
| a | c | |||||
| ZP1 | 0.325 | 0.52 | 31.1 | 8.00 | 0.9933 | 0.73 |
| ZP2 | 0.325 | 0.52 | 27.5 | 10.12 | 0.9110 | 0.64 |
| ZP3 | 0.325 | 0.52 | 25.3 | 12.40 | 0.8935 | 0.42 |
| Sample | P. aeruginosa | S. aureus | p-Value |
|---|---|---|---|
| ZP1 | 10 ± 1.25 | 9 ± 0.81 | <0.05 |
| ZP2 | 18 ± 1.41 | 14 ± 0.47 | |
| ZP3 | 13 ± 0.94 | 12 ± 0.81 |
| Sample | P. aeruginosa | S. aureus | ||
|---|---|---|---|---|
| MIC | MBC | MIC | MBC | |
| ZP1 | 12.5 | 25 | 6.25 | 6.25 |
| ZP2 | 3.75 | 6.25 | 1.5 | 3.75 |
| ZP3 | 6.25 | 12.5 | 3.75 | 6.25 |
Disclaimer/Publisher’s Note: The statements, opinions and data contained in all publications are solely those of the individual author(s) and contributor(s) and not of MDPI and/or the editor(s). MDPI and/or the editor(s) disclaim responsibility for any injury to people or property resulting from any ideas, methods, instructions or products referred to in the content. |
© 2023 by the authors. Licensee MDPI, Basel, Switzerland. This article is an open access article distributed under the terms and conditions of the Creative Commons Attribution (CC BY) license (https://creativecommons.org/licenses/by/4.0/).
Share and Cite
Busila, M.; Musat, V.; Alexandru, P.; Romanitan, C.; Brincoveanu, O.; Tucureanu, V.; Mihalache, I.; Iancu, A.-V.; Dediu, V. Antibacterial and Photocatalytic Activity of ZnO/Au and ZnO/Ag Nanocomposites. Int. J. Mol. Sci. 2023, 24, 16939. https://doi.org/10.3390/ijms242316939
Busila M, Musat V, Alexandru P, Romanitan C, Brincoveanu O, Tucureanu V, Mihalache I, Iancu A-V, Dediu V. Antibacterial and Photocatalytic Activity of ZnO/Au and ZnO/Ag Nanocomposites. International Journal of Molecular Sciences. 2023; 24(23):16939. https://doi.org/10.3390/ijms242316939
Chicago/Turabian StyleBusila, Mariana, Viorica Musat, Petrica Alexandru, Cosmin Romanitan, Oana Brincoveanu, Vasilica Tucureanu, Iuliana Mihalache, Alina-Viorica Iancu, and Violeta Dediu. 2023. "Antibacterial and Photocatalytic Activity of ZnO/Au and ZnO/Ag Nanocomposites" International Journal of Molecular Sciences 24, no. 23: 16939. https://doi.org/10.3390/ijms242316939
APA StyleBusila, M., Musat, V., Alexandru, P., Romanitan, C., Brincoveanu, O., Tucureanu, V., Mihalache, I., Iancu, A.-V., & Dediu, V. (2023). Antibacterial and Photocatalytic Activity of ZnO/Au and ZnO/Ag Nanocomposites. International Journal of Molecular Sciences, 24(23), 16939. https://doi.org/10.3390/ijms242316939


